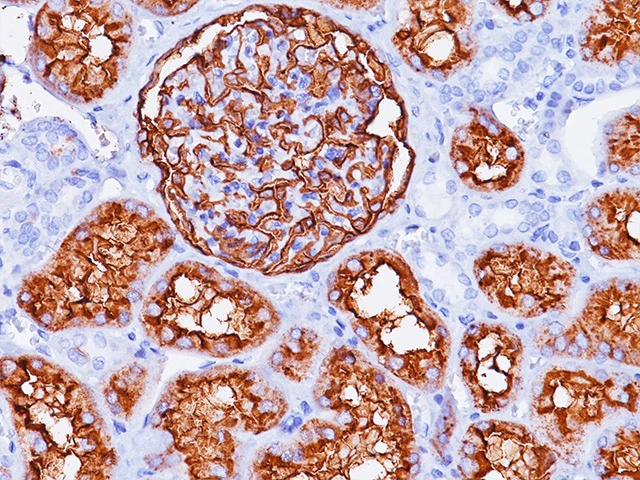
Immunohistochemistry: CD10

تفاصيل التحليل
باقة تحليل الكيمياء النسيجية المناعية (CD10)
باقة تشخيصية متكاملة تستخدم مؤشرات مناعية دقيقة للتمييز بين أورام الجهاز البولي والتناسلي المعقدة، مما يضمن تشخيصاً دقيقاً وخطة علاجية مخصصة لكل مريض.
الصورة التوضيحية المرتبطة بهذا التحليل